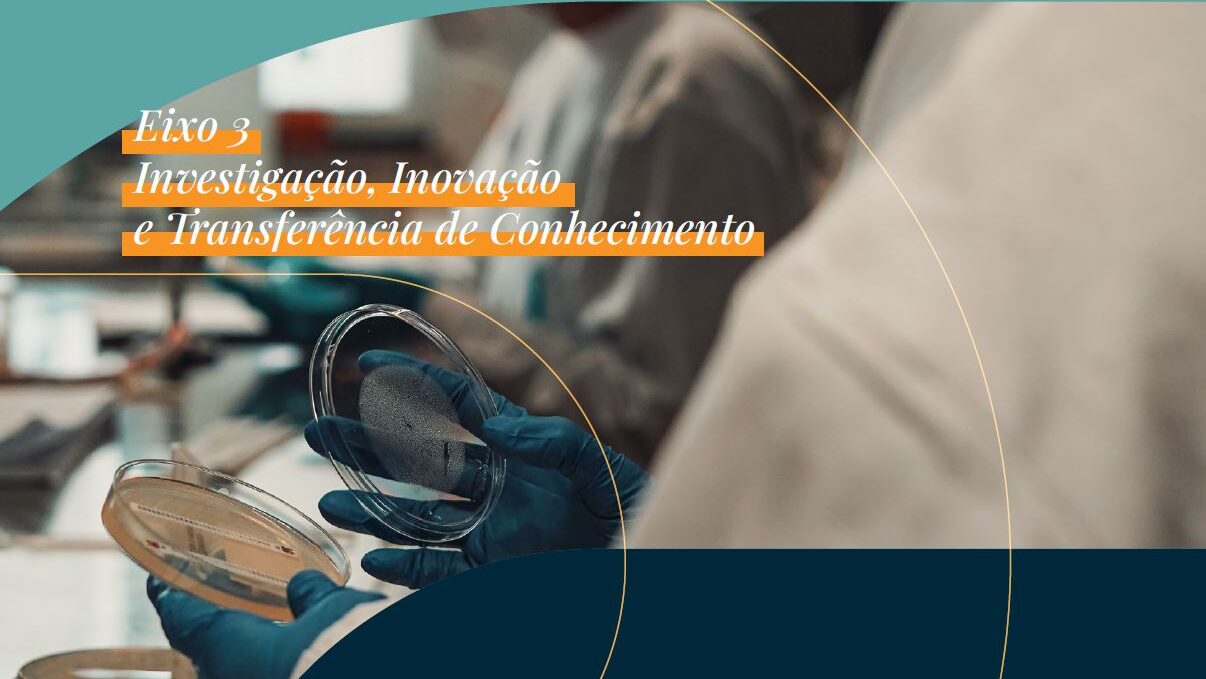
Imagem

O Plano Estratégico do Instituto Politécnico de Coimbra (PE-IPC) é um documento de gestão essencial à implementação da estratégica da instituição para o quadriénio.
Este inclui os objetivos estratégicos e as ações fundamentais à concretização dos eixos prioritários estabelecidos na candidatura da Presidente, Professora Doutora Cândida Malça, para o ciclo 2025-2029.
A concretização do PE-IPC será assegurada pelas ações reportadas anualmente nos Planos e Relatórios de Atividades e aprovados pelo Conselho Geral do IPC.
Documentos para download
O IPC necessita de renovar a sua missão e visão, assumindo a inovação pedagógica, a investigação aplicada e a valorização e partilha do conhecimento produzido como fatores determinantes e competitivos no desenvolvimento local, regional, nacional e internacional.
Para tal, o IPC precisa de implementar políticas que conduzam a uma real e efetiva colaboração e articulação entre as suas Unidades Orgânicas, bem como aumentar as suas redes colaborativas nacionais e internacionais. O incremento destas sinergias permitirá ao IPC alcançar níveis significativos de eficácia institucional, podendo afirmar-se como uma Instituição de Ensino Superior de relevo no desenvolvimento e crescimento da cidade, da região e do país.
É, por isso, essencial renovar a esperança numa instituição mais criativa, dinâmica e audaz na forma como se reinventa e se projeta no futuro.
Um Politécnico em REDE!
Missão
Formar profissionais altamente qualificados e cidadãos globalmente responsáveis, por via de uma oferta formativa de qualidade, do estímulo à investigação aplicada, da ligação estreita à comunidade e do fomento de um ambiente institucional motivador, saudável, justo e inclusivo.
Visão
Tornar o IPC uma referência nacional e internacional no ensino superior, destacando-se pela excelência académica, inovação pedagógica e científica, sustentabilidade e pela forte ligação à comunidade.
Excelência e Qualidade
Elevados padrões no ensino, na investigação e nos serviços prestados à comunidade.
Inovação e Dinamismo
Estímulo constante à criatividade, à adaptação e à renovação institucional.
Integridade e Verdade
Compromisso com a ética, a transparência e a honestidade na gestão e na atuação pública.
Liberdade e Participação
Um ambiente democrático, aberto ao diálogo, à crítica construtiva e à governação partilhada.
Identidade e Pertença
Reforço do sentimento de integração, orgulho e coesão entre todos os que fazem parte do IPC.
Mérito e Justiça
Valorização do esforço, da competência e da equidade, em todas as dimensões institucionais.
Solidariedade e Inclusão
Promoção de uma cultura de respeito, cooperação e igualdade de oportunidades.

Para uma instituição fortemente motivada e coesa, deve ser potenciada uma cultura de colaboração com o envolvimento de todas as partes interessadas, garantindo a sustentabilidade institucional e a transparência, fortalecendo a confiança interna e externa.
Objetivo 1 – Promover uma gestão participada e transparente
Garantir o acesso de informação objetiva, acessível e atempada para construir uma cultura de comunicação clara e aberta através de uma governação colaborativa, com maior transparência e melhores decisões institucionais, fortalecendo a confiança de toda a comunidade.
Ações estratégicas
1. Reforço das políticas para fomentar uma cultura de abertura e responsabilidade institucional.
2. Disseminação de melhores práticas de comunicação.
3. Implementação de políticas e medidas no âmbito do planeamento e da auditoria Interna.
Objetivo 2 – Reforçar a captação e diversidade de fontes de financiamento
Aumento de receita própria obtida através de fontes de financiamento diversificadas para reforço da capacidade institucional, contribuindo para a sustentabilidade financeira e para a afirmação da instituição como um parceiro estratégico de referência em redes e iniciativas de investigação, inovação, desenvolvimento
e cooperação.
Ações estratégicas
4. Definição de políticas para captação de fontes de financiamento diversificadas.
5. Consolidação de uma estrutura central de apoio no IPC, dedicada à prospeção de oportunidades, preparação de candidaturas competitivas e gestão eficiente de projetos.
Objetivo 3- Estabelecer uma relação de proximidade com todas as partes interessadas
Comunidade com sentimento de pertença e identidade institucional para o IPC, de todas as pessoas para todas as pessoas, promovendo uma dinâmica mais interventiva, agregadora, inovadora, global e resiliente.
Ações estratégicas
6. Promoção da identidade e reputação institucional do IPC.
7. Desenvolvimento de campanhas/ações para sensibilização/captação de estudantes nacionais e internacionais.
8. Reforço da confiança mútua e da cooperação com todas as partes interessadas.
Objetivo 4 – Promover uma cultura da qualidade e melhoria contínua
Reforço das políticas de governação no IPC que mitiguem a carga burocrática.
Ações estratégicas
9. Revisão e simplificação dos processos no âmbito do Sistema Interno de Garantia da Qualidade.
10. Certificação no âmbito da Norma ISO 9001:2015, dos procedimentos administrativos dos Serviços Centrais.
11. Certificação no âmbito da Norma ISO 56001:2024 na gestão eficaz da inovação.
12. Certificação no âmbito da Norma NP 4552:2022 para a conciliação da vida profissional, familiar e pessoal.
Objetivo 5 – Promover uma gestão inovadora e sustentávelCapacitar a instituição de práticas de governação e gestão inovadoras, assumindo um compromisso e responsabilidade para o contributo efetivo com o desenvolvimento sustentável (pessoas, planeta, prosperidade, paz e parcerias).
Ações estratégicas
13. Reforço das práticas de responsabilidade social e cidadania.
14. Implementação do Human-Centered Innovation Hub.
15. Formação, informação e sensibilização em matéria de eficiência no uso de recursos junto da comunidade.
16. Adoção de tecnologias eficientes e de baixo consumo carbónico.
17. Monitorização da eficiência no uso de recursos.
18. Racionalização no uso de materiais e consumíveis e incorporação de critérios ecológicos nos processos de aquisição de bens e serviços.
Objetivo 6 – Promover o bem-estar integral da comunidade
Dinamizar a saúde, o desporto e a cultura em parceria com todas as partes interessadas, visando a inclusão e educação.
Ações estratégicas
19. Promoção do acesso aos serviços de saúde integral.
20. Promoção de práticas desportivas e atividade física.
21. Criação e promoção de programas culturais.
Em 2029 na Governação e Sustentabilidade teremos:
Objetivo 1
• uma confiança organizacional fortalecida com toda a comunidade;
• fomentada uma cultura de abertura e responsabilidade institucional;
• adotado as melhores práticas de comunicação;
• práticas de planeamento e auditoria interna integradas em todo o IPC.
Objetivo 2
• políticas implementadas para a captação de fontes de financiamento diversificadas;
• centralizada a estrutura de apoio à gestão de projetos no IPC.
Objetivo 3
• fortalecido a identidade e a reputação institucional do IPC;
• uma nova dinâmica nas campanhas de captação de estudantes nacionais e internacionais;
• a rede de cooperação reforçada com as partes interessadas.
Objetivo 4
• um Sistema Interno de Garantia da Qualidade mais simples, ágil e digital para toda a instituição;
• a certificação pela Norma ISO 9001:2015 nos SC;
• a certificação pelas Normas ISO 56001:2024 e NP 4552:2022.
Objetivo 5
• uma instituição com maior responsabilidade social e de cidadania;
• o Human-Centered Innovation Hub implementado;
• uma comunidade mais eficiente no uso de recursos.
Objetivo 6
• serviços de saúde integral, práticas desportivas e atividade física, e programas culturais acessíveis a toda a comunidade.

O IPC assume o compromisso de adequar e otimizar a sua oferta formativa para responder às exigências e alterações contínuas do mercado de trabalho e sociedade.
Objetivo 7 – Promover ambientes de ensino-aprendizagem inovadores
Promover a existência de uma cultura de autorreflexão e melhoria constante na inovação pedagógica.
Ações estratégicas
22. Criação de um ambiente de valorização da inovação pedagógica.
23. Implementação do prémio de mérito pedagógico.
Objetivo 8 – Modernizar a oferta formativa
Garantir a atualização da oferta formativa do IPC alinhada com as exigências do mercado de trabalho e as tendências científicas e tecnológicas.
Ações estratégicas
24. Adaptação dos planos de estudo às exigências do mundo atual.
25. Promoção da formação alinhada com as necessidades do mercado de trabalho.
26. Monitorização do percurso académico (sucesso/insucesso e abandono escolar) dos estudantes do IPC.
27. Monitorização do percurso profissional dos diplomados do IPC.
Em 2029 na Excelência Pedagógica e Académica teremos:
Objetivo 7
• uma cultura de autorreflexão e de inovação pedagógica em todas as Unidades Orgânicas de Ensino;
• o Prémio de Mérito Pedagógico implementado.
Objetivo 8
• uma dinâmica de atualização da oferta formativa;
• uma articulação permanente com as necessidades do mercado de trabalho;
• políticas de mitigação do insucesso e abandono escolar dos estudantes do IPC.

Num mundo em constante evolução é imperativo que a investigação, a inovação e a transferência de conhecimento se adapte e atualize, permitindo ao IPC estabelecer uma forte ligação ao território, às empresas e à sociedade, para uma atuação de excelência com impacto real e transformador.
Objetivo 9 – Implementar uma agenda de investigação e inovação do IPC
Definir e consolidar uma agenda institucional de investigação e inovação clara, reconhecida e alinhada com prioridades nacionais, europeias e globais.
Ações estratégicas
28. Reforço de parcerias nacionais e internacionais com instituições de investigação de referência, potenciando redes de cooperação e a transferência de conhecimento.
29. Criação de estruturas laboratoriais em rede em cada Unidade Orgânica de Ensino, acessíveis a docentes e investigadores de diferentes áreas científicas.
30. Reforço das políticas de incentivo à investigação.
31. Fortalecimento da qualidade científica e da sustentabilidade dos centros e polos de centros de investigação.
32. Consolidação das práticas de Ciência Aberta e de acesso aberto no IPC, promovendo transparência, reutilização e impacto da investigação produzida.
33. Integração dos estudantes do IPC em atividades de I&D+i, potenciando o desenvolvimento das suas competências científicas e transversais.
Em 2029 na Investigação, Inovação e Transferência de Conhecimento teremos:
Objetivo 9
• ampliado e consolidado as parcerias nacionais e internacionais com instituições de investigação;
• criadas estruturas laboratoriais em rede nas diversas áreas científicas;
• políticas de incentivo à investigação em funcionamento;
• centros e polos de investigação com melhor avaliação;
• uma política de transparência para a investigação produzida, práticas de ciência aberta e de transferência de conhecimento;
• mais estudantes integrados em atividades de I&D+i em todo IPC.
O incremento da capacidade de internacionalização do IPC permitirá aumentar o seu reconhecimento e prestígio junto das congéneres internacionais, promovendo e inovando o ensino, desenvolvimento científico e multiculturalidade
Objetivo 10 – Melhorar a Rede de Parcerias Internacionais
Expansão e reforço da Rede de Parcerias Internacionais para potenciar o ensino, a investigação e a inovação do IPC.
Ações estratégicas
34. Desenvolvimento de acordos bilaterais e multilaterais que fortaleçam a rede de parcerias internacionais.
35. Capacitação da comunidade IPC com competências para atuar em contextos institucionais de âmbito internacional.
36. Promoção da mobilidade académica.
37. Promoção de ambientes inclusivos e multiculturais.
Objetivo 11 – Melhorar as políticas de integração de estudantes, bolseiros, docentes, não docentes e investigadores internacionais
Atrair e reter mais estudantes, bolseiros, docentes, não docentes e investigadores internacionais.
Ações estratégicas
38. Revisão e reforço das políticas e medidas para uma integração eficaz dos estudantes, bolseiros, docentes, não docentes e investigadores internacionais.
Em 2029 na Internacionalização teremos:
Objetivo 10
• acordos bilaterais e multilaterais ampliados;
• uma comunidade IPC com competências para atuar em contextos internacionais;
• aumentado a mobilidade académica;
• centros de investigação e polos de centro de investigação com melhor avaliação;
• aumentado as atividades em ambientes inclusivos e multiculturais.
Objetivo 11
• aumentado o número de estudantes, bolseiros, docentes, não docentes e investigadores internacionais.

A produtividade do IPC, o seu mérito e qualidade dependem fortemente da satisfação individual e coletiva da sua comunidade, pelo que é essencial uma cultura de valorização dos recursos humanos e materiais para promoção do desenvolvimento profissional, científico, artístico, cultural e humano.
Objetivo 12 – Garantir a renovação e o desenvolvimento do talento
Atrair e reter talento em todos os corpos profissionais da Instituição.
Ações estratégicas
39. Definição de políticas para a promoção e divulgação do reconhecimento.
40. Promoção de ações de formação transversais e/ou específicas adequadas aos perfis dos trabalhadores.
41. Aumento da ligação à comunidade, com participação de especialistas de outras entidades.
Objetivo 13 – Promover a inclusão e a cultura de mérito Integração de mecanismos que distingam, valorizem e reconheçam o desempenho profissional dos trabalhadores.
Ações estratégicas
42. Revisão e atualização do processo de avaliação de desempenho do pessoal docente, investigadores e pessoal não docente.
Objetivo 14 – Garantir a transição geracional dos trabalhadores
Facilitar a transferência do conhecimento crítico acumulado para uma transição fluída e eficaz.
Ações estratégicas
43. Definição de políticas e medidas que garantam a transferência do conhecimento e experiência.
44. Criação de programas de mentoria para docentes, investigadores e não docentes.
Objetivo 15 – Estruturar programas de acolhimento aos novos trabalhadores
Integração dos trabalhadores no exercício de novas funções conforme a política institucional.
Ações estratégicas
45. Implementação de mecanismos de partilha de conhecimento/experiência.
Objetivo 16 – Garantir as condições de equidade da comunidade IPC
Governação justa dos campi para assegurar ambientes físicos de trabalho, aprendizagem, lazer e alojamento que permitam uma qualidade de vida e bem-estar da comunidade.
Ações estratégicas
46. Registo completo do património do IPC.
47. Estabelecimento de parcerias com autoridades de ordenamento local/regional para melhorar a interação com a comunidade/campi.
48. Execução de projetos financiados de reabilitação e beneficiação de edifícios, infraestruturas e espaços do IPC.
Objetivo 17 – Garantir a transformação digital
Adotar plataformas digitais integradas que permitam a desburocratização e a otimização dos recursos.
Ações estratégicas
49. Desmaterialização da documentação.
50. Promoção e garantia da interoperabilidade com os sistemas informáticos nucleares.
51. Promoção da transformação digital com infraestruturas modernas e resilientes.
52. Melhoria dos mecanismos de cibersegurança.
Em 2029 nos Recursos Humanos e Materiais teremos:
Objetivo 12
• o corpo profissional mais alinhado com a cultura institucional;
• o corpo profissional com mérito reconhecido;
• o plano de formação adequado aos perfis dos trabalhadores;
• aumentado a ligação à comunidade através de integração de especialistas.
Objetivo 13
• o processo de avaliação de desempenho mais ajustado aos diversos corpos profissionais.
Objetivo 14
• implementado programas de transferência de conhecimento e experiência a nível geracional nos diversos corpos profissionais;• programas de mentoria para docentes, investigadores e não docentes implementados.
Objetivo15
• implementado um programa de acolhimento para novos trabalhadores nos diversos corpos profissionais.
Objetivo 16
• todo o património IPC devidamente registado;
• melhorado a interação entre campus;
• aumentado as candidaturas e execução de projetos financiados de reabilitação e beneficiação de edifícios, infraestruturas e espaços do IPC.
Objetivo 17
• desmaterializada toda a documentação da instituição;
• todos os sistemas informáticos nucleares interoperacionais;
• infraestruturas modernas e resilientes alinhadas com a transformação digital;
• mecanismos de cibersegurança melhorados.









